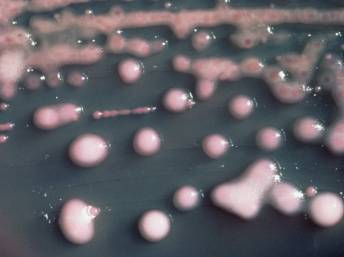

Una nueva bacteria resistente a casi todos los antibióticos acaba de ser descubierta en los hospitales británicos y pone en alerta al mundo entero al despertar el temor de una posible propagación. Identificada por primera vez en 2009, ya fue localizada en 37 pacientes británicos y también ha sido reportada en Estados Unidos, Holanda, Australia y Canadá.
Identificada por primera vez en un paciente sueco que había sido hospitalizado en India, la bacteria NDM-1 “Nueva Delhi metalo becta latamasaya” ya fue localizada en 37 pacientes en el Reino Unido. Todo apunta a que el micro-organismo procedente de India y Pakistán llegó a Gran Bretaña incubada en el cuerpo de algunos pacientes que viajaron hacia esos países para someterse a tratamientos médicos.
La bacteria resiste a casi todos los tipos de antibióticos, incluyendo aquellos reservados a las urgencias y al tratamiento de infecciones multirresistentes. RFI conversó con el profesor Tim Walsh, científico que descubrió la resistencia de este microbio por primera vez en el 2009. Estas son sus principales respuestas:
“La situación real, es que hemos identificado esta nueva clase de resistencia bacteriana que proviene de la introducción de una bacteria en otra y estas bacterias en las que se penetra son microbios comunes que todas las personas tenemos. Es lo que denominamos flora normal. Cada uno de nosotros tiene dentro de su organismo cerca de 100 trillones de bacterias de las cuales la mayoría se encuentran en el intestino y un buen porcentaje de estas ha demostrado ser resistente a los antibióticos, por lo tanto el potencial de propagación es bastante alto.”
“No sabemos como se extendió en India, lo cierto es que la forma en la cual esta bacteria se transmite puede ser de un individuo a otro ó de un ambiente a una persona. Es lo que denominamos transmisión vertical, es decir que las personas podrían ingerir esta bacteria, ya sea en la comida ó en el agua.“
“Al parecer se propagó a través de personas que viajaron a la India para someterse a procedimientos quirúrgicos, como es el caso de los pacientes portadores de la bacteria de Canadá, Estados Unidos y Australia. En el Reino Unidos hemos reportado 37 casos de los cuales sabemos 17 se han sometido a este tipo de procedimientos en India, lo cual nos indica que hay una fuerte conexión entre el adquirir este tipo de resistencia y el ir a tratamientos médicos a la India.“
“En mi opinión esta bacteria tiene el potencial de convertirse en un serio problema de salud pública. Primero porque cuando adquiere este primer tipo de resistencia se convierte virtualmente resistente a todos los tipos de antibióticos excepto dos. En segundo lugar, tiene que ver el hecho de que todas las personas tengamos esta bacteria como flora intestinal, por lo cual si se hace resistente su fortaleza se podría mantener entre la población. Y por último, si miramos hacia el futuro podremos ver que virtualmente no hay ningún antibiótico que pueda combatir esta bacteria. Estos tres factores sugieren que deberíamos estar preocupados. No tenemos que tener pánico, es decir se puede viajar a la India, de hecho es un lugar maravilloso con gente increíble. Simplemente hay que ser cuidadoso con el agua que se beba, lo que se coma y dónde se coma.”
“Lo que deberíamos hacer ahora a nivel de los pacientes es tratar de explorar si podemos combinar ciertos antibióticos que tienen aún un efecto positivo. Tal vez con los dos a los que la bacteria es aún resistente.”
“En un nivel global lo que necesitamos es utilizar toda la tecnología que se encuentra a nuestra disposición, iniciar un sistema público global de fondos y ejercer más presión en los gobiernos y en las empresas farmacéuticas para que tomen este tipo de resistencia bacteriana en serio ya que existe una posibilidad de que se agoten estos dos únicos antibióticos que tenemos por el momento. Es un escenario preocupante.”
“En el Reino Unido tenemos una política de antibióticos prudente lo cual quiere decir que no los utilizamos innecesariamente. Igualmente tenemos una buena política de control de infecciones y si algún paciente se presenta con este tipo de bacteria se tomarán las medidas indicadas para evitar su propagación.”...
Leer más en rfi